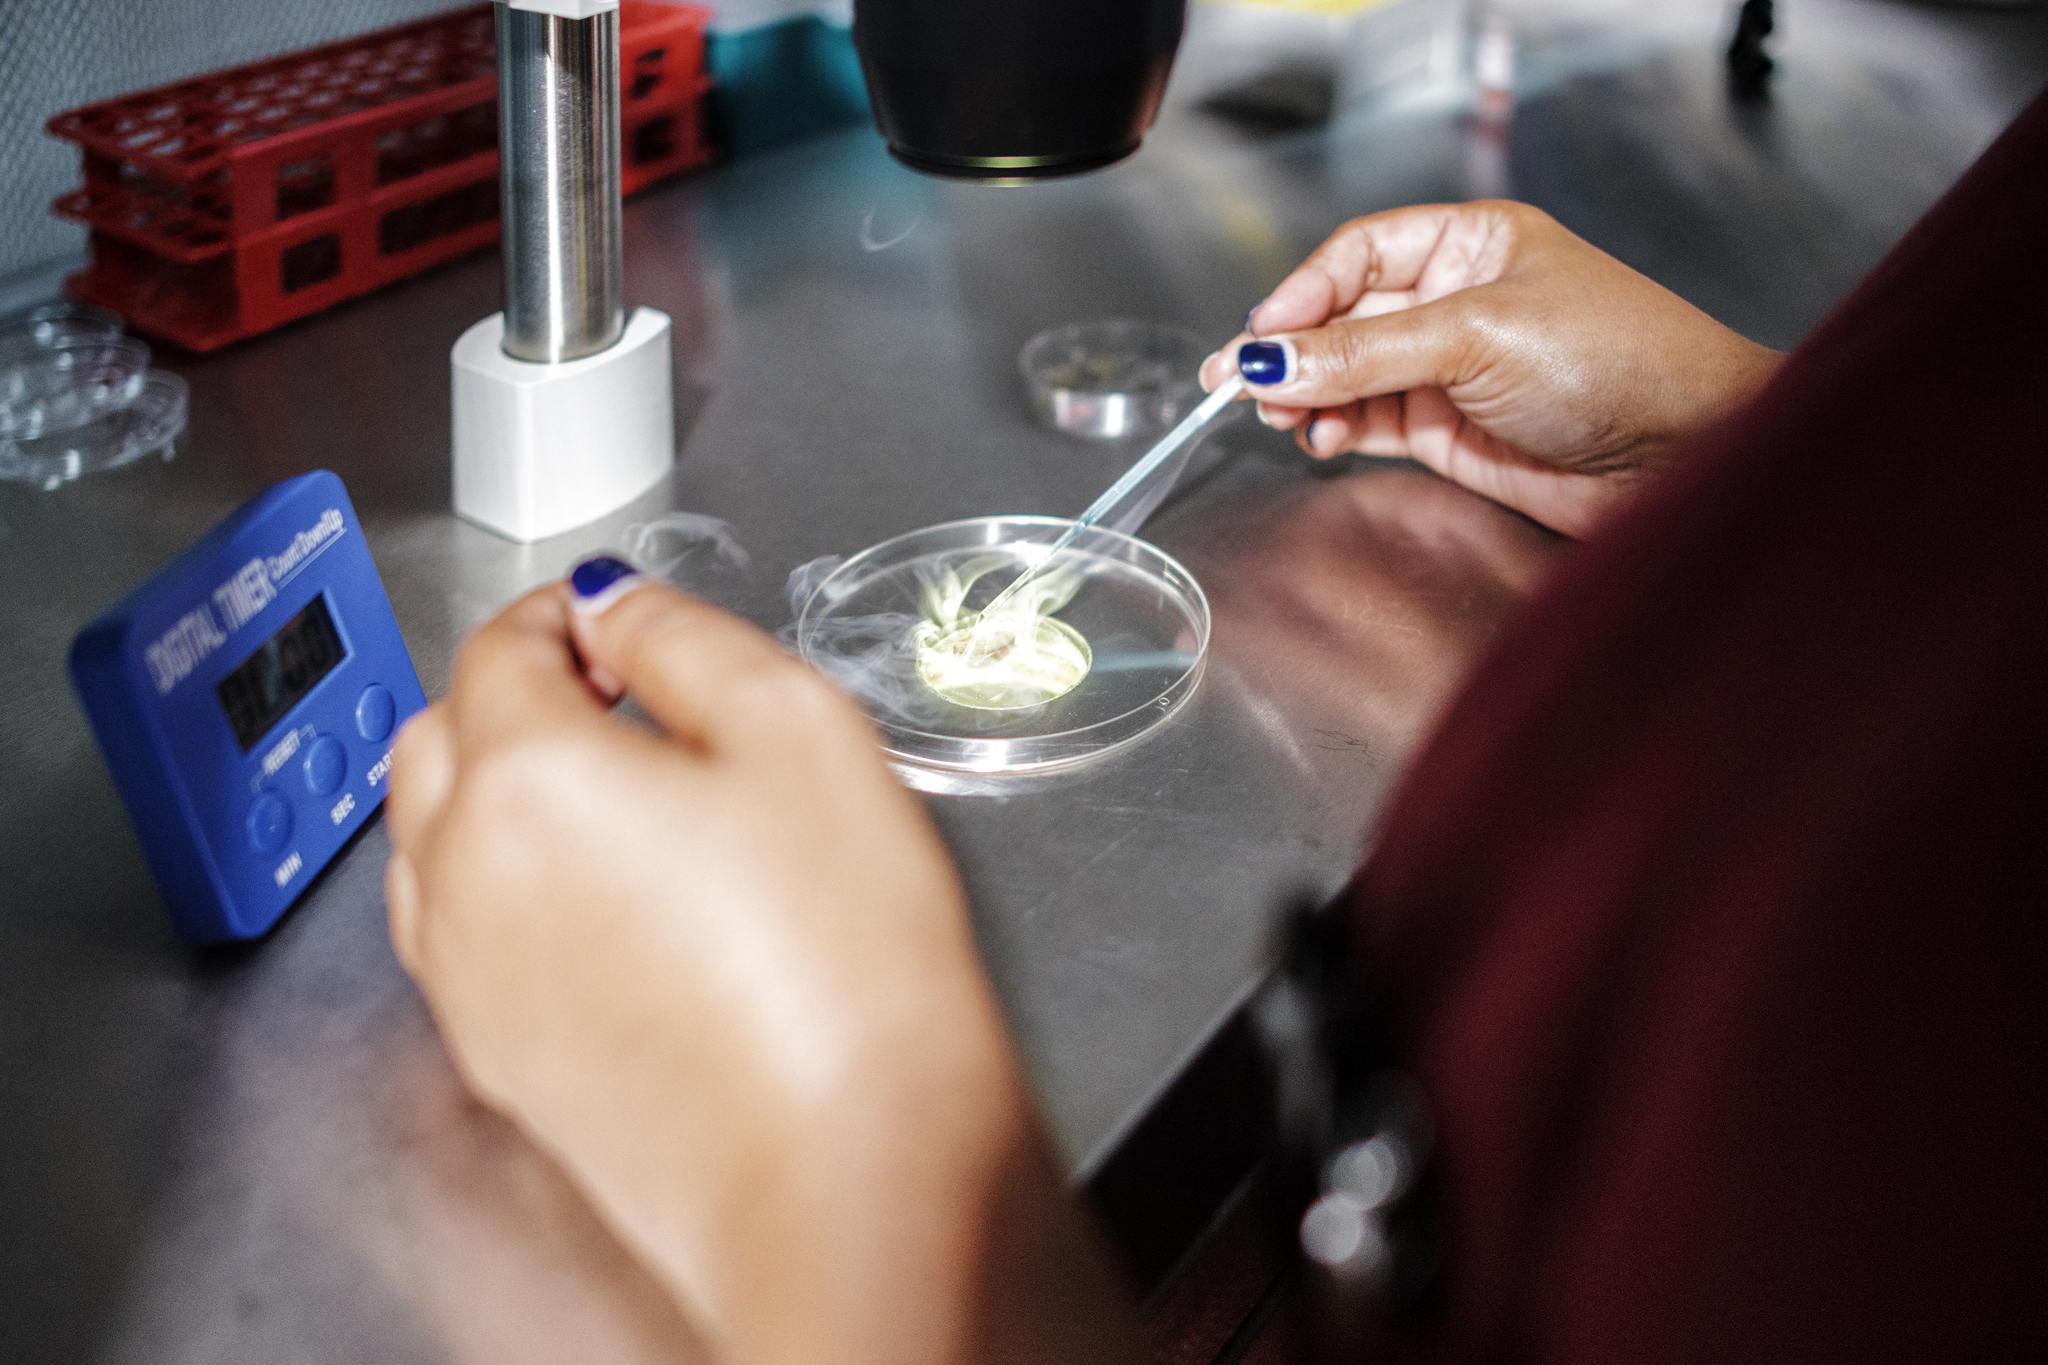

Judge orders gynaecologist to provide DNA after suspected insemination with own sperm

A court in Bruges has ordered a gynaecologist to take part in a comparative DNA test after strong suspicions that he used his own sperm in an artificial insemination.
The court order followed a complaint by a man who was conceived through an artificial insemination procedure carried out by the gynaecologist.
The procedure should have been carried out using sperm from an anonymous donor. However, using comparisons in online DNA databases, the man was able to show in a scientifically valid way that the gynaecologist was very likely his father.
The gynaecologist will have to pay 1,500 euros a day if he refuses to take part in the DNA test
The gynaecologist, who tried to invoke the right to donor anonymity, will have to pay a fine of 1,500 euros a day if he refuses to take part in the DNA test, the Bruges court of first instance has ruled.
The court had to weigh the right to know one's biological parents against a sperm donor's right to privacy and anonymity. The judge ruled that in this particular case the former outweighed the latter.
Donor anonymity
The principle of anonymity usually applies to both sides, the judge said, with neither the sperm donor nor the prospective parents knowing each other. In this case, the gynaecologist may have broken this principle by inseminating his patient with his own sperm.
"The legitimate expectation of anonymity invoked cannot prevail"
The judge said it was "striking" that the gynaecologist was so adamant about donor anonymity, given the strong suspicion that he himself had breached this principle when inseminating the plaintiff's mother.
"The legitimate expectation of anonymity invoked by him cannot prevail, since by his own actions he appears to have trampled on the legitimate expectation of the plaintiff's mother that she would be inseminated with sperm from an anonymous donor," the judge said.
Right to appeal
An expert has been appointed to carry out comparative DNA testing, but the decision cannot be enforced yet as the gynaecologist still has the right to appeal.
The judge said the gynaecologist's DNA profile could not be used for any other purpose, as every donor child should be able to choose whether they want to investigate their parentage.
"The plaintiff should not make that choice for them by collecting matches and possibly informing those involved of information they may not want to know," said the judge.
#FlandersNewsService | © AFP PHOTO GEORGES GOBET
Related news